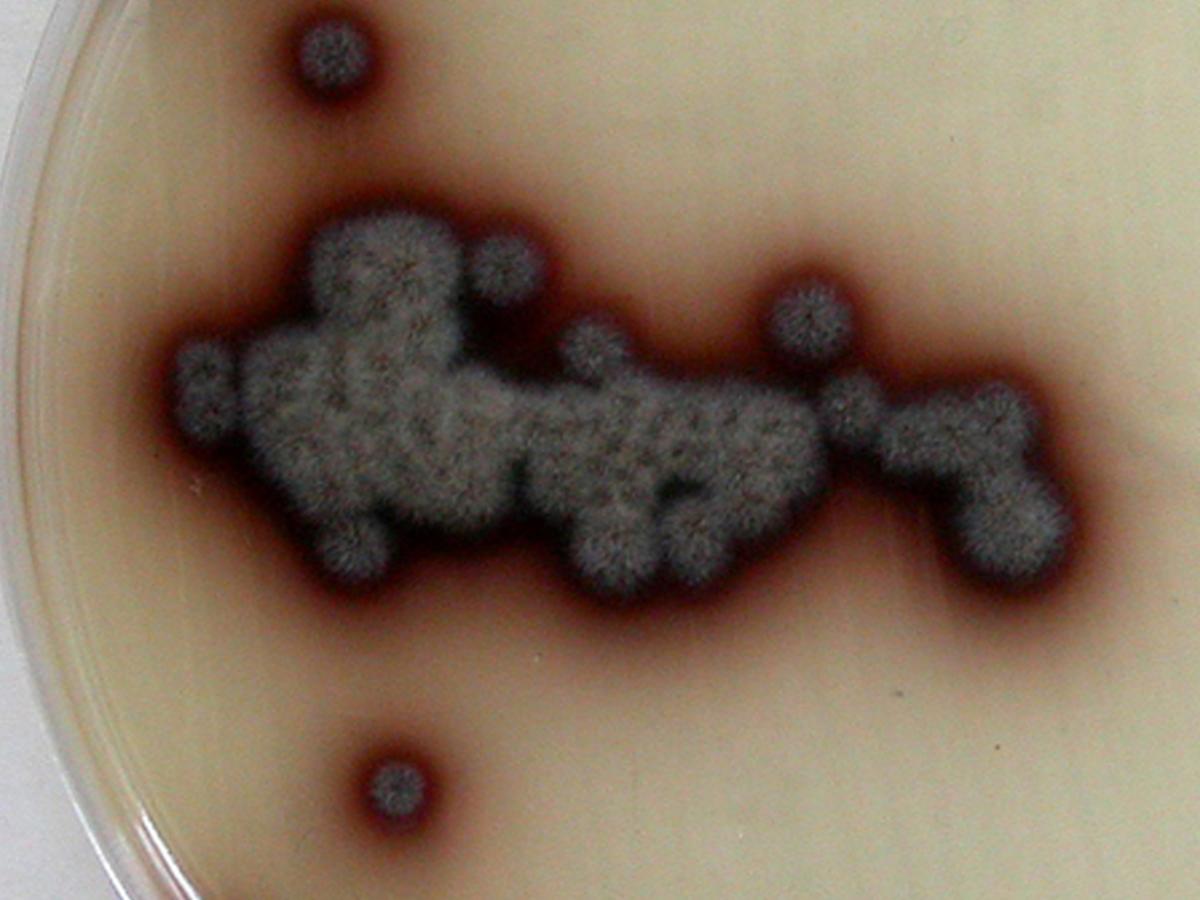
Culture

Status message
Correct! Excellent, you have really done well. Please find additional information below.
Unknown 48 = Verruconis gallopava
Culture: Colonies of Verruconis gallopava are smooth to suede-like, dry, flat, tobacco-brown to brownish-black with a dark brown diffusible pigment. Optimum growth at 35C, tolerant to 40C. RG-2 organism
Microscopy: Hyphae are brown with relatively thick walls. Conidiophores are mostly cylindrical to acicular, sometimes poorly differentiated, bearing a few conidia at the tip. Conidia are two-celled, subhyaline to pale brown, smooth-walled to verrucose, cylindrical to clavate, constricted at the septum, 11-18 x 2.5-4.5 µm in size, with the apical cell wider than the basal cell. A remnant of a denticle may also be seen at the conidial base.

Comment: Verruconis gallopava is a well recognised species and has been reported as an avian pathogen, especially in poultry. Occasional human infections have also been reported.
About Verruconis Back to virtual assessment